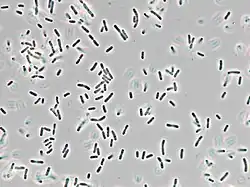

Delftia tsuruhatensis
| Delftia tsuruhatensis | |
|---|---|
| Scientific classification | |
| Domain: | Bacteria |
| Kingdom: | Pseudomonadati |
| Phylum: | Pseudomonadota |
| Class: | Betaproteobacteria |
| Order: | Burkholderiales |
| Family: | Comamonadaceae |
| Genus: | Delftia |
| Species: | D. tsuruhatensis
|
| Binomial name | |
| Delftia tsuruhatensis Shigematsu et al. 2003, sp. nov.[1]
| |
| Type strain | |
| ATCC BAA-554, DSM 17581, IFO 16741, NBRC 16741, T7[2] | |
Delftia tsuruhatensis is a Gram-negative, rod-shaped, catalase- and oxidase-positive, motile bacterium from the Comamonadaceae family. It was first isolated from a wastewater treatment plant in Japan in 2003.[3] D. tsuruhatensis is an opportunistic and emergent pathogen.[4] All documented human infections are healthcare-associated.[4][5][6]
Biology and biochemistry
Cells are slightly curved, short rod-shaped cells that occur singly or in pairs. Cells are 0.7–1.2 μm wide and 2.4–4.0 μm long.[3]
D. tsuruhatensis can degrade phenolic compounds[7] and aniline,[8] which are often pollutants of soil and water.
Biofilm interactions
D. tsuruhatensis can inhibit quorum sensing and biofilm formation, which could inform new therapeutic drugs against antibiotic-resistant bacteria.[9] D. tsuruhatensis inhibits quorum sensing and suppresses biofilm formation against Pseudomonas aeruginosa and other pathogens.[9][10] These activities increase P. aeruginosa's susceptibility to antibiotics by 2 to 3 times.[11]
Applications
In 2023, researchers published evidence in Science that D. tsuruhatensis prevents the development of malaria in mosquitos by secreting harmane. Mosquitos infected by the bacteria had 75% fewer Plasmodium oocysts and featured infection rates one third those of uninfected mosquitoes.[12][13][14][15]
See also
- Serratia – a genus of bacteria that can be genetically modified to prevent malaria.
- Wolbachia – a genus of bacteria that can be used to control dengue.
References
- ^ "Genus Delftia". List of Prokaryotic Names with Standing in Nomenclature. Retrieved 17 December 2016.
- ^ "Strain Passport: NBRC 16741 Delftia tsuruhatensis". StrainInfo. Archived from the original on 28 May 2017. Retrieved 17 December 2016.
- ^ a b Shigematsu T, Yumihara K, Ueda Y, Numaguchi M, Morimura S, Kida K (2003). "Delftia tsuruhatensis sp. nov., a terephthalate-assimilating bacterium isolated from activated sludge". International Journal of Systematic and Evolutionary Microbiology. 53 (Pt 5): 1479–83. doi:10.1099/ijs.0.02285-0. PMID 13130036.
- ^ a b Ranc, A; Dubourg, G; Fournier, PE; Raoult, D; Fenollar, F (March 2018). "Delftia tsuruhatensis, an Emergent Opportunistic Healthcare-Associated Pathogen". Emerging Infectious Diseases. 24 (3): 594–596. doi:10.3201/eid2403.160939. PMC 5823324. PMID 29460754.
- ^ Tabak, Omur; Mete, Bilgul; Aydin, Selda; Mandel, Nil Molinas; Otlu, Baris; Ozaras, Resat; Tabak, Fehmi (2013). "Port-related Delftia tsuruhatensis bacteremia in a patient with breast cancer". The New Microbiologica. 36 (2): 199–201. ISSN 1121-7138. PMID 23686127.
- ^ Preiswerk, Benjamin; Ullrich, Silvia; Speich, Rudolf; Bloemberg, Guido V.; Hombach, Michael (2011). "Human infection with Delftia tsuruhatensis isolated from a central venous catheter". Journal of Medical Microbiology. 60 (2): 246–248. doi:10.1099/jmm.0.021238-0. ISSN 0022-2615. PMID 20965913.
- ^ Juárez-Jiménez, Belén; Manzanera, Maximino; Rodelas, Belén; Martínez-Toledo, Maria Victoria; Gonzalez-López, Jesus; Crognale, Silvia; Pesciaroli, Chiara; Fenice, Massimiliano (2010-06-01). "Metabolic characterization of a strain (BM90) of Delftia tsuruhatensis showing highly diversified capacity to degrade low molecular weight phenols". Biodegradation. 21 (3): 475–489. doi:10.1007/s10532-009-9317-4. ISSN 1572-9729. PMID 19946734. S2CID 2130491.
- ^ Sheludchenko, M. S.; Kolomytseva, M. P.; Travkin, V. M.; Akimov, V. N.; Golovleva, L. A. (2005-09-01). "Degradation of Aniline by Delftia tsuruhatensis 14S in Batch and Continuous Processes". Applied Biochemistry and Microbiology. 41 (5): 465–468. doi:10.1007/s10438-005-0083-8. ISSN 1608-3024. PMID 16240651. S2CID 20548636.
- ^ a b Malešević, Milka; Di Lorenzo, Flaviana; Filipić, Brankica; Stanisavljević, Nemanja; Novović, Katarina; Senerovic, Lidija; Polović, Natalija; Molinaro, Antonio; Kojić, Milan; Jovčić, Branko (2019-11-11). "Pseudomonas aeruginosa quorum sensing inhibition by clinical isolate Delftia tsuruhatensis 11304: involvement of N-octadecanoylhomoserine lactones". Scientific Reports. 9 (1): 16465. Bibcode:2019NatSR...916465M. doi:10.1038/s41598-019-52955-3. ISSN 2045-2322. PMC 6848482. PMID 31712724.
- ^ Singh, Vijay K.; Mishra, Avinash; Jha, Bhavanath (2017). "Anti-quorum Sensing and Anti-biofilm Activity of Delftia tsuruhatensis Extract by Attenuating the Quorum Sensing-Controlled Virulence Factor Production in Pseudomonas aeruginosa". Frontiers in Cellular and Infection Microbiology. 7: 337. doi:10.3389/fcimb.2017.00337. ISSN 2235-2988. PMC 5526841. PMID 28798903.
- ^ Hentzer, M. (2003-08-01). "Attenuation of Pseudomonas aeruginosa virulence by quorum sensing inhibitors". The EMBO Journal. 22 (15): 3803–3815. doi:10.1093/emboj/cdg366. ISSN 1460-2075. PMC 169039. PMID 12881415.
- ^ OFFORD, CATHERINE (3 Aug 2023). "Microbe Stops Mosquitoes Harboring Malaria Parasite".
- ^ Huang, Wei; Rodrigues, Janneth; Bilgo, Etienne; Tormo, José R.; Challenger, Joseph D.; De Cozar-Gallardo, Cristina; Pérez-Victoria, Ignacio; Reyes, Fernando; Castañeda-Casado, Pablo; Gnambani, Edounou Jacques; Hien, Domonbabele François de Sales; Konkobo, Maurice; Urones, Beatriz; Coppens, Isabelle; Mendoza-Losana, Alfonso (2023-08-04). "Delftia tsuruhatensis TC1 symbiont suppresses malaria transmission by anopheline mosquitoes". Science. 381 (6657): 533–540. doi:10.1126/science.adf8141. hdl:10044/1/105278. ISSN 0036-8075. PMID 37535741. S2CID 260440907.
- ^ Offord, Catherine (3 August 2023). "Microbe stops mosquitoes from harboring malaria parasite". Science.
- ^ "Chance discovery helps fight against malaria". BBC News. 2023-08-04. Retrieved 2023-08-04.
External links